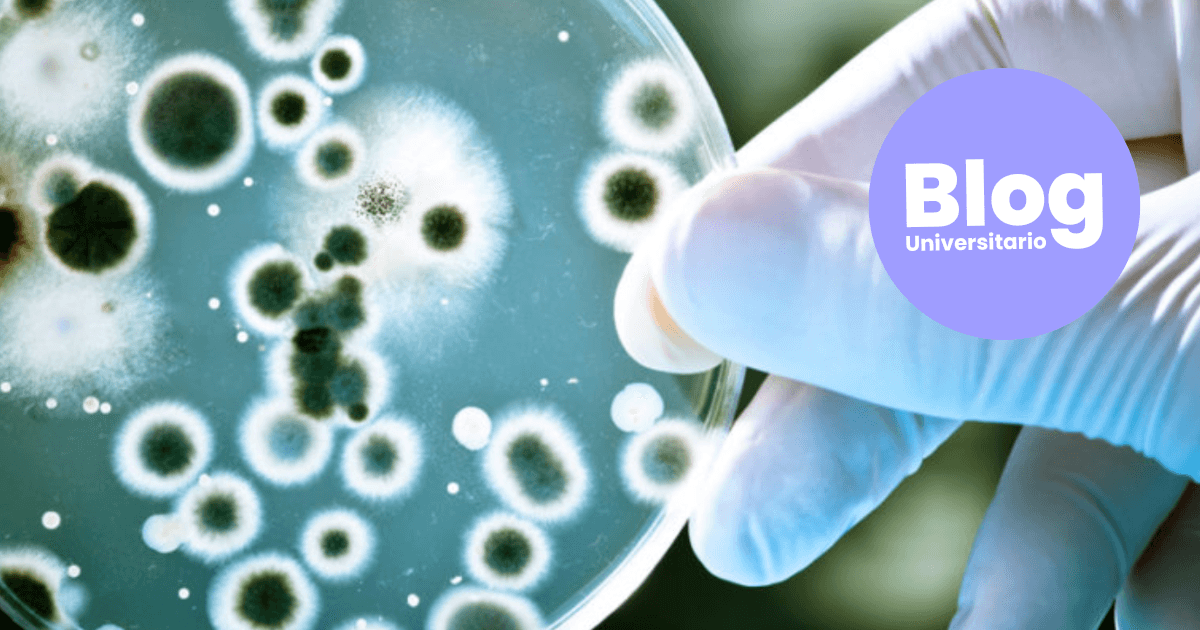
Imagen del artículo: Estudiá Microbiología: el estudio de lo invisible al ojo humano

Carrera de Microbiología
Tiempo para emplearse:
0.0 meses
Tasa de desempleo:
1%
Salario promedio:
¢1193814
OLAP-3082 2022
La microbiología es el estudio de aquellos seres vivos pequeños cuyo tamaño está por debajo del alcance del ojo humano; por lo que el estudio de esta disciplina radica en la metodología y el estudio de dichos microorganismos. Es decir: la microbiología surge a raíz del uso del microscopio y los descubrimientos que esto involucra.
El especialista en microbiología se enfoca en la investigación, desarrollo y control de políticas relacionadas con los microorganismos, las enfermedades infecciosas que pueden provocar y los procesos en los que estos seres se encuentran involucrados.
- Puede regular los microorganismos que se involucran en la industria alimenticia.
- Controla y asegura la calidad en cuanto a productos agrícolas, ambientales y farmacéuticos.
- Es capaz de manipular y aprovechar microorganismos en ciertos productos para solucionar problemas en sectores específicos.
- Logra trabajar en campos relacionados con enfermedades y malestares en el terreno nacional e internacional.
- Sectores agrícolas, ambientales, alimenticios, farmacéuticos y demás campos relacionados con salud humana.
- Implementando tecnologías orientadas al control microbiológico y sanitario del desarrollo de productos.
- En docencia universitaria.
- Dirigiendo proyectos investigativos relacionados a la temática.
Herramientas
¿Donde puedo estudiar Microbiología en Costa Rica?
información
¡Nuevo!
Enviá tus consultas de forma inmediata
Dejá tus datos una única vez al crear tu cuenta y hacé consultas inmediatas
O bien, llená todos tus datos manualmente
Ingresá o creá una cuenta desde el auth central de Aurens.
Pronto recibirás una respuesta
Un representante de la institución se pondrá en contacto con vos para seguir el proceso.
¿Cómo te gustaría que te contacten?
Correo
Llamada
¿Ya consideraste carreras similares?
Diplomado
Diplomado
Diplomado
Bachillerato
LicenciaturaOpciones para estudiar esta carrera:

















.png&w=3840&q=75)

.png&w=3840&q=75)
.png&w=3840&q=75)
.png&w=3840&q=75)